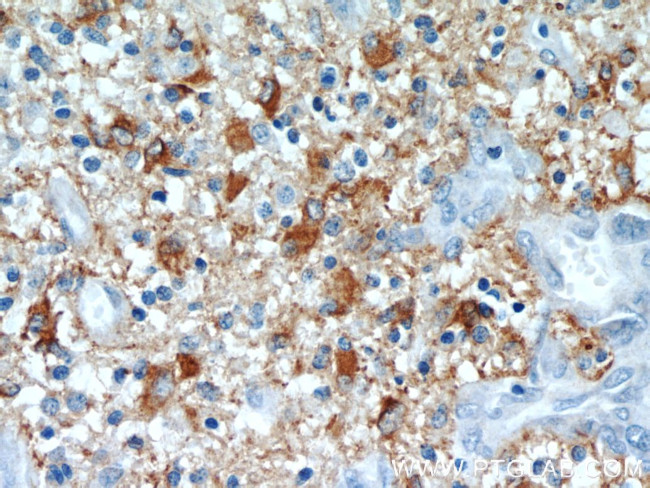
GFAP Antibody in Immunohistochemistry (Paraffin) (IHC (P))

Search
Proteintech
GFAP Polyclonal Antibody
{{$productOrderCtrl.translations['antibody.pdp.commerceCard.promotion.promotions']}}
{{$productOrderCtrl.translations['antibody.pdp.commerceCard.promotion.viewpromo']}}
{{$productOrderCtrl.translations['antibody.pdp.commerceCard.promotion.promocode']}}: {{promo.promoCode}} {{promo.promoTitle}} {{promo.promoDescription}}. {{$productOrderCtrl.translations['antibody.pdp.commerceCard.promotion.learnmore']}}
产品信息
23935-1-AP
种属反应
已发表种属
宿主/亚型
分类
类型
抗原
偶联物
形式
浓度
规格
纯化类型
保存液
内含物
保存条件
运输条件
产品详细信息
Immunogen sequence: MERRRITSA ARRSYVSSGE MMVGGLAPGR RLGPGTRLSL ARMPPPLPTR VDFSLAGALN AGFKETRASE RAEMMELNDR FASYIEKVRF LEQQNKALAA ELNQLRAKEP TKLADVYQAE LRELRLRLDQ LTANSARLEV ERDNLAQDLA TVRQKLQDET NLRLEAENNL AAYRQEADEA TLARLDLERK IESLEEEIRF LRKIHEEEVR ELQEQLARQQ VHVELDVAKP DLTAALKEIR TQYEAMASSN MHEAEEWYRS KFADLTDAAA RNAELLRQAK HEANDYRRQL QSLTCDLESL RGTNESLERQ MREQEERHVR EAASYQEALA RLEEEGQSLK DEMARHLQEY QDLLNVKLAL DIEIATYRKL LEGEENRITI PVQTFSNLQI RETSLDTKSV SEGHLKRNIV VKTVEMRDGE VIKESKQEHK DVM (1-432 aa encoded by BC013596)
靶标信息
GFAP (Glial fibrillary acidic protein) is a member of the class III intermediate filament protein family. GFAP is heavily and specifically expressed in astrocytes and certain astroglia of the central nervous system, in satellite cells of peripheral ganglia, and in non-myelinating Schwann cells of peripheral nerves. In addition, neural stem cells strongly express GFAP. Antibodies to GFAP are very useful as markers of astrocytic cells. In addition, many types of brain tumor, presumably derived from astrocytic cells, heavily express GFAP. GFAP is also found in the lens epithelium, Kupffer cells of the liver, in some cells in salivary tumors and has been reported in erythrocytes. GFAP is used as a marker to distinguish astrocytes from other glial cells during development. Mutations in this gene cause Alexander disease, a rare disorder of astrocytes in the central nervous system. Alternative splicing of the GFAP gene results in multiple transcript variants encoding distinct isoforms.
仅用于科研。不用于诊断过程。未经明确授权不得转售。
生物信息学
蛋白别名: Astrocyte or Intermediate Filament Protein; FLJ45472; GFAP; GFAP epsilon; Glial fibrillary acidic protein; Glial Fibrillary Acidic Protein (GFAP); glial fibrillary acidic protein alpha; intermediate filament; intermediate filament protein; unnamed protein product
基因别名: AI836096; ALXDRD; GFAP
UniProt ID: (Human) P14136, (Rat) P47819, (Mouse) P03995
Entrez Gene ID: (Human) 2670, (Rat) 24387, (Mouse) 14580